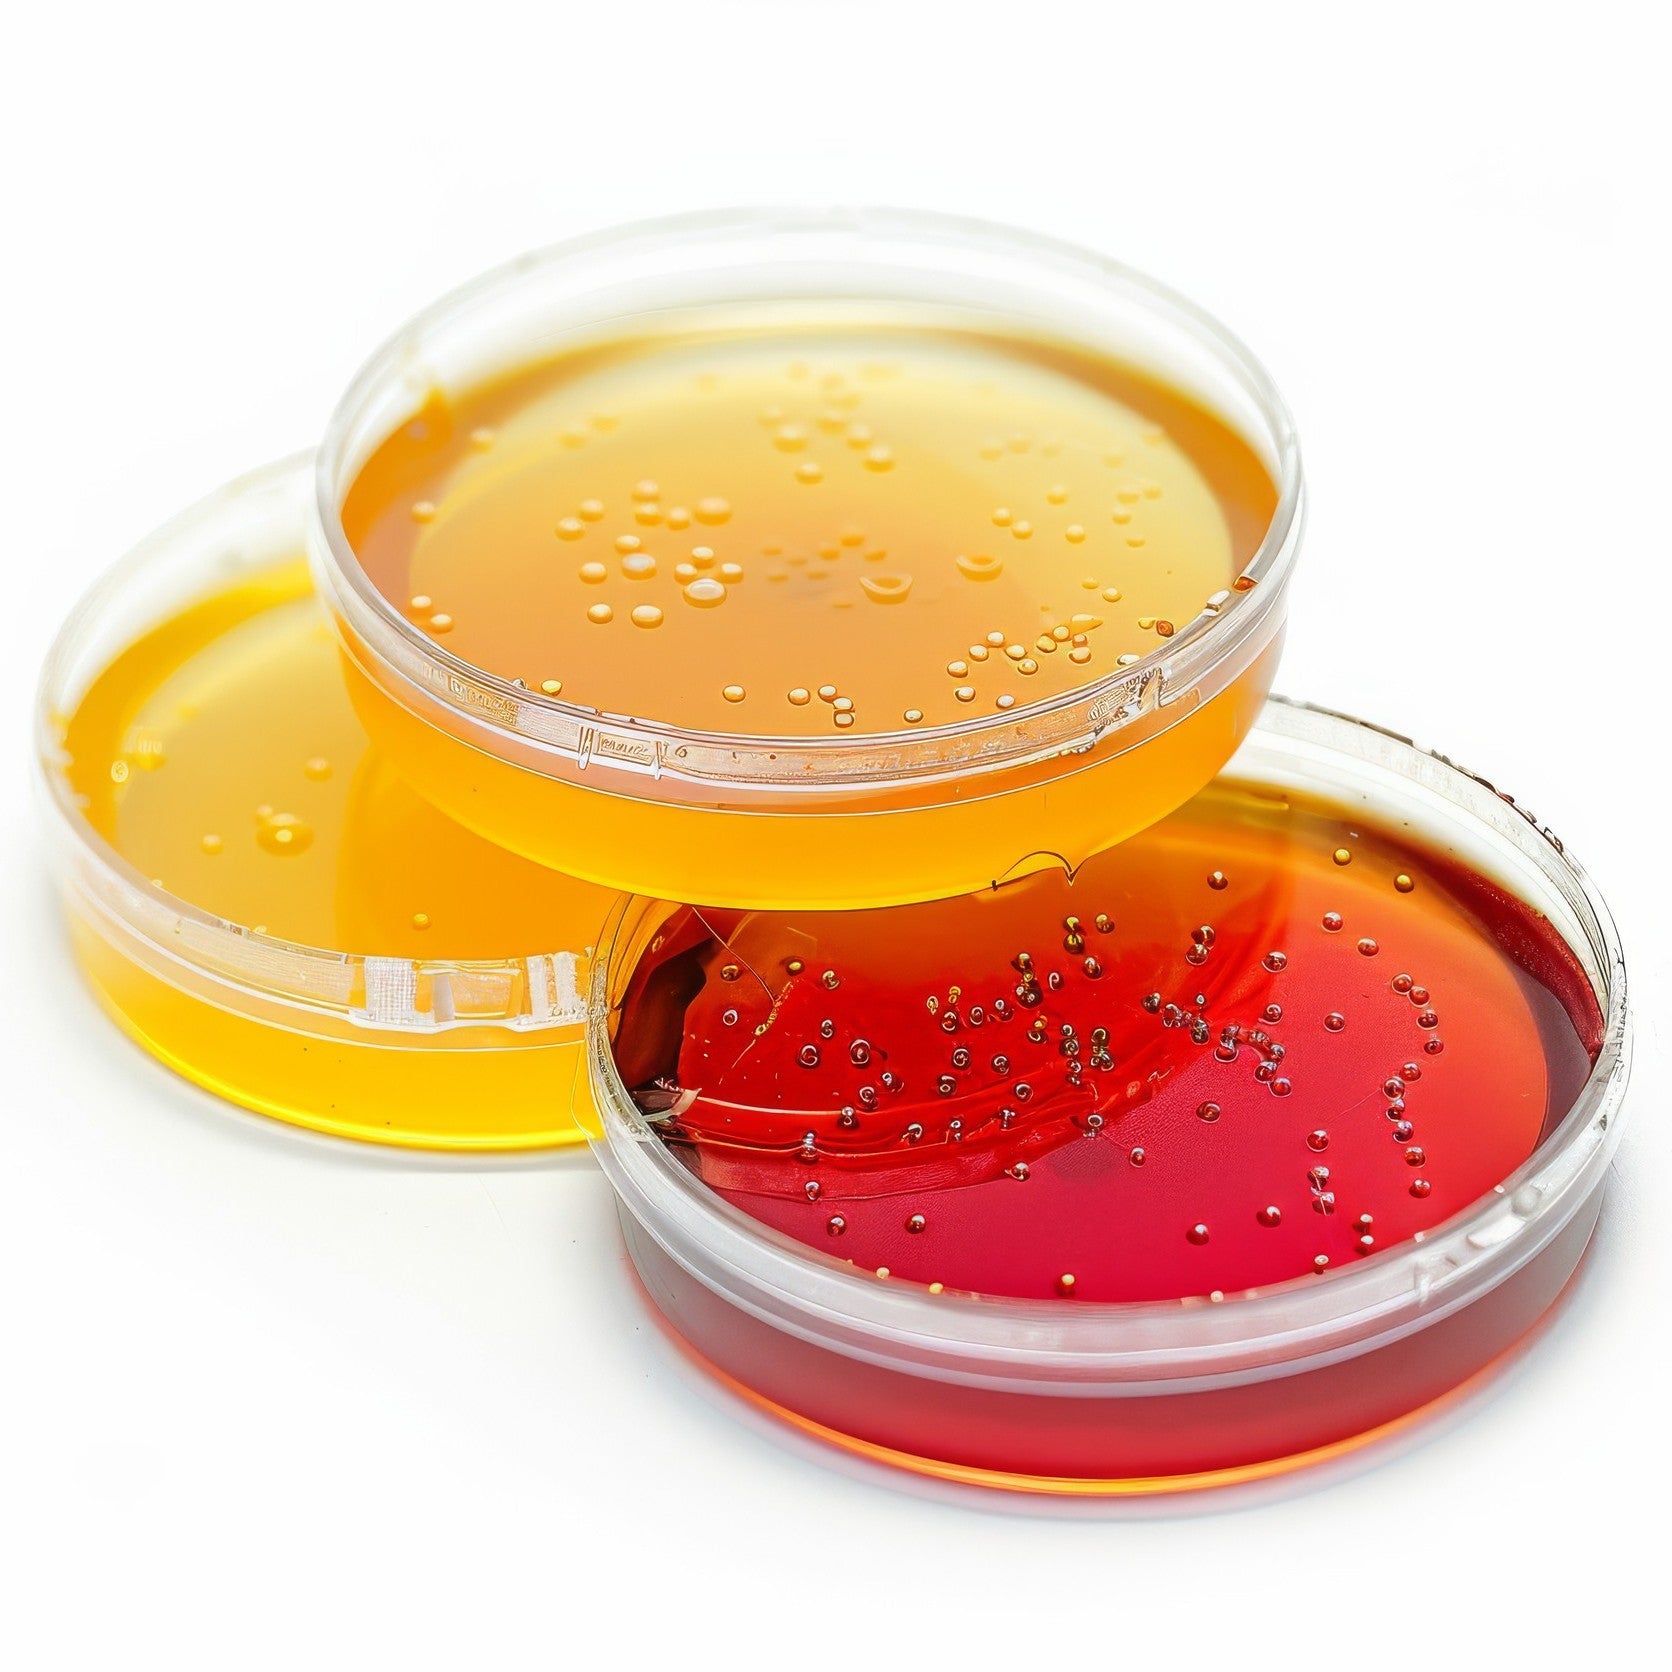
Cell Culture

Our suppliers
Why Shop With Vareum?
We ensure you get the right items from the brands you trust
One Platform, All Your Laboratory Procurement Needs.
Expert Advisory Support
Get guidance from industry specialists with 30+ years of combined experience
Global Reach
Access 1.5M+ products from verified suppliers and ship to 50+ countries.
Trusted & Ethical Sourcing
Work only with verified, transparent suppliers that meet industry standards
Flexible Payment Options
Pay securely by credit card, PayPal, or bank transfer, whatever works for you
Enjoy 10% Discount On Orders Over $2500
Top Best Sellers
Laboratory Equipment & Instruments
Orbi-Shaker™ Mp Microplate Shaker With 4 Position Platform
Choose your option
Choose your option
Choose your option
Choose your option
Choose your option
Cell Culture Flask, 250 mL, 75 cm², PS
Choose your option
CELLSTAR® Cell Culture Flask, TC, PS, 50 mL, 25 cm²
Choose your option

















Shop this Molecular

((Cys31,Nva34)-Neuropeptide Y (27-36))2

(+)-Biotinamidohexanoic acid hydrazide


Shop this Proteins

Abaloparatide, Human PTHrP Peptide


Shop this look

0.5-20µL Pipette, Ovation, (E12) Electronic Multichannel, Yellow

0.2-2.0µL Pipette, Ovation, M (Mechanical)

10 Hole L/F Headplate for Omni Vessels

106P Roller Drum/18mm Tubes 12 dia. for Low Profile Base"


Shop this

** SPECIAL ORDER ITEM ** Bottle with Screwcap, Wide Mouth, LDPE, Graduated, 1000mL

** SPECIAL ORDER COLOR ** Microscope Slides, White Glass, 25 x 75mm, Positive Charged, 45ֲ° Beveled Edges, Safety Corners, Orange Frosted, 72/Box, 20 Boxes/Case (10 Gross)

** SPECIAL ORDER ITEM ** Bottle with Screwcap, Wide Mouth, LDPE, Graduated, 2000mL

0.1 mL 96 Well PCR Plate, Full Skirt, Clear, H1 Notch, Sterile, 5/bag, 25/pk, 100/cs

** SPECIAL ORDER SIZE ** Microscope Cover Glass, 24mm x 32mm, # 2 Thickness, 1 oz./Vacuum Pack, 10 Packs/Box (10 oz.)
New Arrivals
Screen Quest™ Calbryte-520 Probenecid-Free and Wash-Free Calcium Assay Kit
Choose your option
Glass microfiber capsule filters
Whatman™ HEPA-Cap Vent Filters
Choose your option
Laboratory Equipment & Instruments
Balance, Precision, 6000g x 0.01g, Internal Calibration, 100-240V, 50-60Hz, Rechargeable Internal Battery
Choose your option
(1→3)-ß-D-Glucan Inhibiting Buffer
Choose your option
AGL1 (pSoup) Agrobacterium ElectroCompetent Cells
Choose your option
CytoSoft® Imaging 96-well Plate, Elastic Modulus 16 kPa
Choose your option
0.5ML TRI CODED TUBE 96 MAT STERILIZATION
Choose your option

From Antibodies & Reagents To Lab Equipment
VAREUM brings everything your laboratory needs together in one place.
Example product title

Making Research Product Selection Simple and Efficient
From procurement to supply optimization — we manage your lab inventory so your team can focus on discovery.
Example product title
Customer Service
Monday–Friday, 8:00 AM – 6:00 PM Eastern Time, excluding major U.S. holidays.
Call Us
Get in Touch
info@vareum.com
Address
USA
30 N Gould St, STE R, Sheridan, WY 82801, USA
ISRAEL
Alumot 6, Omer Industrial Park, IL8500833